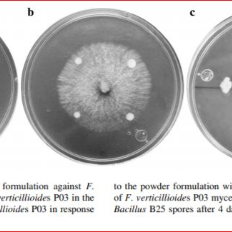
Granulate formulation protocol

Oct 24, 2020
Granulate formulation protocol
- Andreea S1
- 1University of Groningen
- iGEM Groningen 2020

Protocol Citation: Andreea S 2020. Granulate formulation protocol. protocols.io https://dx.doi.org/10.17504/protocols.io.bkrpkv5n
License: This is an open access protocol distributed under the terms of the Creative Commons Attribution License, which permits unrestricted use, distribution, and reproduction in any medium, provided the original author and source are credited
Protocol status: Other
The protocol was developed based on literature and has not been tested yet.
Created: September 03, 2020
Last Modified: October 24, 2020
Protocol Integer ID: 41487
Keywords: various formulations of bacillus subtili, bacillus subtili, bacillus b25 spore, bacterial inoculant, based powder formulation, bacillus mycoide, powder formulation, formulation protocol bioformulation, viable bacteria, formulated product like powder, microbiology, number of viable bacteria, bacteria, granulate formulation, various formulation, efficacy against the pathogenic fungus fusarium verticillioide, formulated product, survival with the granulate formulation, pathogenic fungus fusarium verticillioide, colony forming unit, crops other than pesticide, present in every formulated product, fungal cell, powder, pesticide, crop, soil fertility, fatty acid analysis
Abstract
Bioformulation is used in agriculture for various reasons like soil fertility, plant growth promotion, and suppression of phytopathogens. The bacterial inoculants are applied as a formulated product like powder, spray, or pellet. This is a green strategy that is being developed as a less harmful method to protect crops other than pesticides. In the paper published by Alvarez et al, 2016, they developed a talc-based powder formulation based on Bacillus B25 spores and evaluated some of its characteristics, like shelf life and efficacy against the pathogenic fungus Fusarium verticillioides.
Citation
LINK
Colony Forming Units (CFU) is a unit that is used in microbiology to estimate the number of viable bacteria or fungal cells in a sample. It also depends on their ability to multiply under controlled conditions. In the paper published by El-Hassan and Gowen, 2006, they analyzed various formulations of Bacillus subtilis by counting the CFU of B. subtilis present in every formulated product.
Citation
LINK
Fatty acid analysis is an important means to characterize fats and oils and to determine the total fat content. The resulst can be used to identify the Bacillus mycoides strain in the soil and determine its survival with the granulate formulation.
Citation
LINK
Bacterium Inoculum
Grow a single colony of bacteria in an assay tube with 5 mL of Luria Broth (LB) medium
Incubate it in an orbital shaker at 200 rev.min-1 at 30 °C for 18:00:00 .
After bacterial growth, take a 500 mL Erlenmeyer flask and add 100 mL of LB medium in it.
Add 1 mL of the culture (1 % (v/v) ) in the flask and incubate at 30 °C and 200 rev.min-1 for 24:00:00 , until an optical density of close to 1 is obtained.
Spore Production
Add 100 mL of Difco Sporulation Medium (DSM; 5gl-1 peptone, 3gl-1 yeast extract, 1gl-1 KCl and 0.12 gl-1 MgSO47H2O) in a 500 mL Erlenmeyer flask.
Sterilize this DSM medium at 121 °C and 1.5 psi for 00:15:00 .
Add 1 mL each of: 1 Molarity (M) Ca(NO3)2, 10 millimolar (mM) MnCl2.4H2O and 1 millimolar (mM) FeSO4
Inoculate with 1X106 c.f.u ml-1 of the bacterial strain. Keep the culture conditions at 30 °C and 200 rev.min-1 for 72:00:00 .
Powder Formulation
Mix talc (which will be the carrier) with, carboxy-methyl-cellulose (CMC; 1% w/w), CaCO3 (15% w/w) and glucose (0.25% w/w) in powder form.
Autoclave the mixture at 121 °C and 15 psi for 00:15:00 .
Mix the same material with the bacterial spore suspension and dry at 55 °C for 36:00:00 .
Using sterile porcelain mortar and pestle pulverize the formulation.
Pack it in plastic bags and store it at room temperature.
CFU determination
Colony Forming Units (CFU) can be determined by estimating the OD of spore suspension using a tube-reading spectrophotometer adjusted at 1.978 [corresponding to 8.5 · 1010 CFU/ml] at 600nm absorbance wavelength
The formulation will be placed on sterile aluminum foil in pans and air-dried for 24:00:00 with occasional stirring in a laminar airflow cabinet.
Dried formulations (35% moisture content) of B. mycoides will be passed through a 250μm mesh sieve to attain the desired particle size.
Pack in sterilized polypropylene bags, seal and store atRoom temperature prior to use.
Count CFUs to estimate the number of viable propagules of B. mycoides using the standard dilution platin method.
STD dilution method
Take three 1 g aliquots of the dried powder and place in 99 mL sterile PBST solution (this will include PBS + 0.05 % (v/v) Tween 20). Stir magnetically at high speed for 00:15:00 . Now dilute this suspension with approximately and take 0.2 mL of this suspension and plate on Nutrient Agar (NA) media.
Fatty acid analysis
By performing saponification, methylation, and then extracting we can obtain fatty acid methylesters from wet biomass.
Next, separate the fatty acid methylester mixtures by using a microbial identification system. Peaks can be automatically integrated, and the Microbial ID will calculate the fatty acid names and percentages.
Citations
Martínez-Álvarez, J. C., Castro-Martínez, C., Sánchez-Peña, P., Gutiérrez-Dorado, R., & Maldonado-Mendoza, I. E.. Development of a powder formulation based on Bacilluscereus sensu lato strain B25 spores for biological control of Fusarium verticillioides in maize plants.
https://doi.org/10.1007/s11274-015-2000-5S. A. El-Hassan and S. R. Gowen. Formulation and Delivery of the Bacterial Antagonist Bacillus subtilis for Management of Lentil Vascular Wilt Caused by Fusarium oxysporum f. sp. lentis
https://doi.org/10.1111/j.1439-0434.20Friedrich von Wintzingerode, Frederick A. Rainey, Reiner M. Kroppenstedt, Erko Stackebrandt. Identification of environmental strains of Bacillus mycoides by fatty acid analysis and species-specific 16S rDNA oligonucleotide probe
https://doi.org/10.1111/j.1574-6941.1997.tb00437.x